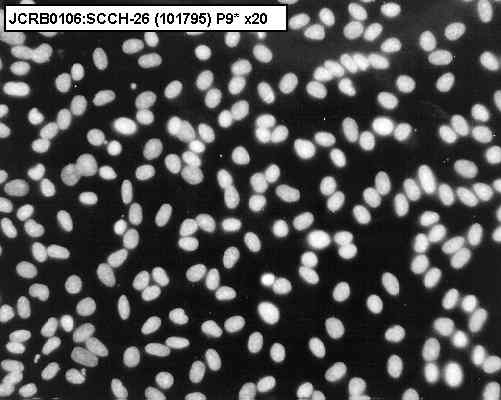

JCRB0106 SCCH-26
細胞情報
Important Notice(s)細胞種類:一般細胞 (細胞分譲手数料はこちら)
| 細胞番号(JCRB) | JCRB0106 | 細胞名 | SCCH-26 |
|---|---|---|---|
| 生物種(日本語) | ヒト | 組織名(日本語) | 神経系 |
| コメント(日本語) | 神経芽細胞腫 | プロフィール | Human neuroblastoma cell line. |
| 別名 | (eliminated) | 動物名 | human |
| 系統名 | 学名・属名 | Homo | |
| 学名・種小名 | sapiens | 性別 | |
| 年齢・月齢 | 細胞識別情報 | available | |
| (癌)原発組織名 | neural | 病歴情報 | neuroblastoma |
| 転移の有無(Y/N) | No | (癌)転移組織名 | |
| 遺伝的性質 | neuroblastoma | 細胞寿命 | infinite |
| クライシスPDL | 形態 | fibroblast-like | |
| 一般性状 | neuroblastoma | 細胞分類 | tumor |
| 細胞樹立者名 | Kaneko,Y. | 細胞寄託者 | Kaneko,Y. |
| 分譲時制限 | Not regulated | コメント | Other name was discarded because of the personal ID. |
| 入手年 | 1987 | 培養培地 | ES medium with 10% calf serum. The ES medium is Eagle's MEM (containing L-glutamine) supplemented with 0.2 mM each non essential amino acids, 1 mM sodium pyruvate, and 0.1 mg/L cyanocobalamin (vitamine B12). |
| 継代方法 | Cells are treated with 0.02% EDTA and 0.25% trypsin. | 継代時細胞数 | split ratio=1/10 |
| 人種 | 炭酸ガス濃度 | 5 % | |
| 採取組織名 | 組織型 |
| ウイルスDNA・RNA検出検査 (Detection of virus genome fragment by Real-time PCR) | |||||||||
|---|---|---|---|---|---|---|---|---|---|
| ウイルスDNA 検出検査 |
tested | ウイルスRNA 検出検査 |
tested | ||||||
| CMV | - | parvoB19 | - | HCV | - | HTLV-1 | - | ||
| EBV | + | HBV | - | HIV-1 | - | HTLV-2 | - | ||
| HHV6 | - | HTLV-1 | - | HIV-2 | - | HAV | - | ||
| HHV7 | - | HTLV-2 | - |
-/negative. +/positive. nt/not tested. (positive (+) does not immediately mean the production of infectious viral particles.) |
|||||
| BKV | - | HIV-1 | - | ||||||
| JCV | - | HIV-2 | - | ||||||
| ADV | - | HPV18 | - | ||||||
| Notes | EBV(low copy) | ||||||||
| Reference | |
|---|---|
| Pubmed id:2121721 | Monoclonal antibodies to disialogangliosides: characterization of antibody-mediated cytotoxicity against human melanoma and neuroblastoma cells in vitro. Kawashima I,Tada N,Fujimori T,Tai T J Biochem. 1990 Jul;108(1):109-15 |
| Pubmed id:7105014 | Adenine phosphoribosyltransferase deficiency in cultured mouse mammary tumor FM3A cells resistant to 4-carbamoylimidazolium 5-olate. Koyama H,Kodama H Cancer Res. 1982 Oct;42(10):4210-4 |
| Images |
|---|
![]() ![]() ![]() ![]() ![]() ![]() ![]() ![]() ![]() ![]() ![]() |
LOT Information
生細胞率、増殖速度、細胞濃度はバンクでのロット作製時の実測値として記していますが、保証値ではございません。また、倍加時間は継代間で計測したラフな値です。Viability/Growth rate/Cell number are represented as actual values measured at lot presentation in JCRB, but are not guaranteed values. Additionally, the doubling time is a rough value measured during passages.
| 細胞番号 | JCRB0106 | 細胞名 | SCCH-26 |
|---|---|---|---|
| 培養ロット番号 | 101795 | 培養種別 | distribution |
| 培地 | ES medium with 10% fetal bovine serum (JRHB B1B1062) | 培養温度 | 37 C |
| 継代時細胞数(濃度) | 4.0x10^5 cells/sq.cm. | 継代方法 | Mechanical dispersion by pipetting |
| 増殖速度 | NT | 凍結時生細胞濃度 | 2.07x10^6 |
| 凍結時生細胞率 | 使用抗生物質 | Kanamycine 60ug/ml | |
| 継代数 | P9* | PDL数(プライマリ) | NT |
| マイコプラズマ検出 | - | 細菌汚染検出 | - |
| 真菌汚染検出 | - | アイソザイム検査・動物名 | NT |
| 染色体モード | NT | 染色体情報 | NT |
| 表面抗原 | NT | DNA Profile (STR) | |
| 接着性 | Yes | 導入外部遺伝子 | NT |
| 凍結培地 | Culture medium with 5% dimethyl sulfoxide (DMSO) | 炭酸ガス濃度 | |
| 解凍後生細胞率 | 追加情報 |
| Images |
|---|
![]() ![]() ![]() ![]() ![]() ![]() ![]() ![]() ![]() |
| 細胞番号 | JCRB0106 | 細胞名 | SCCH-26 |
|---|---|---|---|
| 培養ロット番号 | 033092 | 培養種別 | distribution |
| 培地 | ES medium with 10% fetal calf serum | 培養温度 | 37 C |
| 継代時細胞数(濃度) | 1x10^6 cells/ml | 継代方法 | 0.02 % EDTA + 0.25 % trypsin |
| 増殖速度 | 凍結時生細胞濃度 | 3.6x10^6 | |
| 凍結時生細胞率 | 68.2 | 使用抗生物質 | free |
| 継代数 | P5* | PDL数(プライマリ) | |
| マイコプラズマ検出 | - | 細菌汚染検出 | - |
| 真菌汚染検出 | - | アイソザイム検査・動物名 | NT |
| 染色体モード | NT | 染色体情報 | NT |
| 表面抗原 | NT | DNA Profile (STR) | |
| 接着性 | 導入外部遺伝子 | ||
| 凍結培地 | Culture medium with 5% DMSO | 炭酸ガス濃度 | 5% |
| 解凍後生細胞率 | 追加情報 |
| 細胞番号 | JCRB0106 | 細胞名 | SCCH-26 |
|---|---|---|---|
| 培養ロット番号 | 102590 | 培養種別 | distribution |
| 培地 | ES + FCS 10% | 培養温度 | 37 |
| 継代時細胞数(濃度) | split ratio:1/10 | 継代方法 | 0.02% EDTA and 0.25% trypsin. |
| 増殖速度 | NT | 凍結時生細胞濃度 | 1.0x10^6 |
| 凍結時生細胞率 | NT | 使用抗生物質 | free |
| 継代数 | P7* | PDL数(プライマリ) | |
| マイコプラズマ検出 | - | 細菌汚染検出 | NT |
| 真菌汚染検出 | NT | アイソザイム検査・動物名 | NT |
| 染色体モード | 染色体情報 | NT | |
| 表面抗原 | DNA Profile (STR) | ||
| 接着性 | 導入外部遺伝子 | ||
| 凍結培地 | 炭酸ガス濃度 | ||
| 解凍後生細胞率 | 追加情報 |
| 細胞番号 | JCRB0106 | 細胞名 | SCCH-26 |
|---|---|---|---|
| 培養ロット番号 | 111987 | 培養種別 | distribution |
| 培地 | ES + FCS 10% | 培養温度 | 37 |
| 継代時細胞数(濃度) | split ratio:1/10 | 継代方法 | 0.02% EDTA and 0.25% trypsin. |
| 増殖速度 | NT | 凍結時生細胞濃度 | 8x10^5 |
| 凍結時生細胞率 | 65% | 使用抗生物質 | KM |
| 継代数 | P4* | PDL数(プライマリ) | |
| マイコプラズマ検出 | - | 細菌汚染検出 | - |
| 真菌汚染検出 | - | アイソザイム検査・動物名 | G6PD,LD,NP |
| 染色体モード | 染色体情報 | NT | |
| 表面抗原 | DNA Profile (STR) | ||
| 接着性 | 導入外部遺伝子 | ||
| 凍結培地 | 炭酸ガス濃度 | ||
| 解凍後生細胞率 | 追加情報 |
| 細胞番号 | JCRB0106 | 細胞名 | |
|---|---|---|---|
| 培養ロット番号 | 03082000 | 培養種別 | distribution |
| 培地 | ES medium (Nissui Seiyaku) with 10% calf serum | 培養温度 | 37 C |
| 継代時細胞数(濃度) | 6-14 x 10^4 cells/ml | 継代方法 | 0.25% trypsin and 0.02% EDTA. Growth retards at high cell density. Passage at 30-50% confluency. |
| 増殖速度 | 3 days | 凍結時生細胞濃度 | 1.6 x 10^6 |
| 凍結時生細胞率 | 53 | 使用抗生物質 | free |
| 継代数 | P7 | PDL数(プライマリ) | |
| マイコプラズマ検出 | - | 細菌汚染検出 | - |
| 真菌汚染検出 | - | アイソザイム検査・動物名 | Confirmed as human by NP, G6PD (type B), AST. |
| 染色体モード | 染色体情報 | ||
| 表面抗原 | DNA Profile (STR) | ||
| 接着性 | 導入外部遺伝子 | ||
| 凍結培地 | 炭酸ガス濃度 | ||
| 解凍後生細胞率 | 追加情報 |